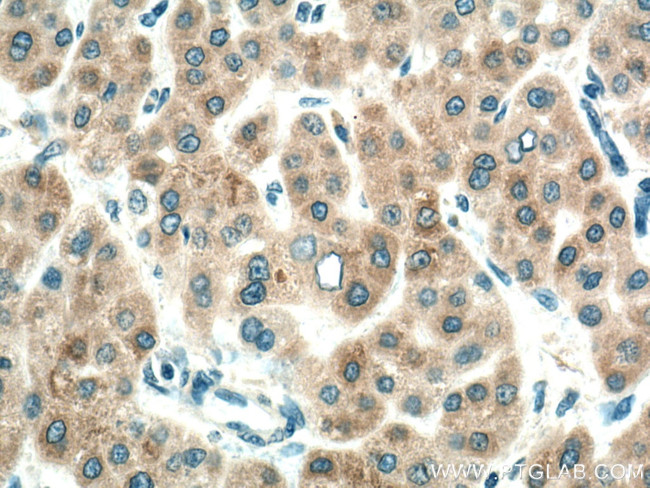
CYP7A1 Antibody in Immunohistochemistry (Paraffin) (IHC (P))

Search
Proteintech
CYP7A1 Polyclonal Antibody
{{$productOrderCtrl.translations['antibody.pdp.commerceCard.promotion.promotions']}}
{{$productOrderCtrl.translations['antibody.pdp.commerceCard.promotion.viewpromo']}}
{{$productOrderCtrl.translations['antibody.pdp.commerceCard.promotion.promocode']}}: {{promo.promoCode}} {{promo.promoTitle}} {{promo.promoDescription}}. {{$productOrderCtrl.translations['antibody.pdp.commerceCard.promotion.learnmore']}}
产品信息
18054-1-AP
种属反应
已发表种属
宿主/亚型
分类
类型
抗原
偶联物
形式
浓度
规格
纯化类型
保存液
内含物
保存条件
运输条件
产品详细信息
Immunogen sequence: RPPVSSNSKT AAWVTEGMYS FCYRVMFEAG YLTIFGRDLT RRDTQKAHIL NNLDNFKQFD KVFPALVAGL PIHMFRTAHN AREKLAESLR HENLQKRESI SELISLRMFL NDTLSTFDDL EKAKTHLVVL WASQANTIPA TFWSLFQMIR NPEAMKAATE EVKRTLENAG QKVSLEGNPI CLSQAELNDL PVLDSIIKES LRLSSASLNI RTAKEDFTLH LEDGSYNIRK DDIIALYPQL MHLDPEIYPD PLTFKYDRYL DENGKTKTTF YCNGLKLKYY YMPFGSGATI CPGRLFAIHE IKQFLILMLS YFELELIEGQ AKCPPLDQSR AGLGILPPLN DIEFKYKFKH L
靶标信息
CYP7A1 is a member of the cytochrome P450 superfamily of enzymes. The cytochrome P450 proteins are monooxygenases which catalyze many reactions involved in drug metabolism and synthesis of cholesterol, steroids and other lipids. This endoplasmic reticulum membrane protein catalyzes the first reaction in the cholesterol catabolic pathway in the liver, which converts cholesterol to bile acids. This reaction is the rate limiting step and the major site of regulation of bile acid synthesis, which is the primary mechanism for the removal of cholesterol from the body.
仅用于科研。不用于诊断过程。未经明确授权不得转售。
生物信息学
蛋白别名: 24-hydroxycholesterol 7-alpha-hydroxylase; Cholesterol 7-alpha-hydroxylase; Cholesterol 7-alpha-monooxygenase; cholesterol 7alpha-hydroxylase; CYPVII; Cytochrome P450 7A1; cytochrome P450, family 7, subfamily A, polypeptide 1; cytochrome P450, subfamily VIIA polypeptide 1
基因别名: CP7A; CYP7; CYP7A1; CYPVII
UniProt ID: (Human) P22680
Entrez Gene ID: (Human) 1581